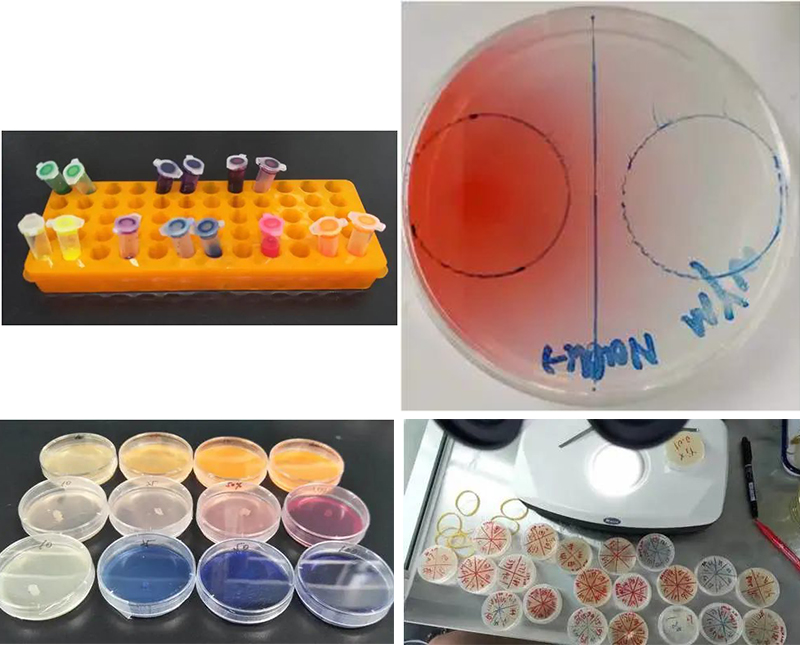
未标题-2.jpg

潞河中学斯坦福生物项目研究社团成立于2018年,依托于“斯坦福大学模式创新型研究人才培养中学联动实验室”项目。该项目是由通州区教委牵头,潞河中学承办的一种创新型人才培养模式探索。该项目以在细胞生物学(神经发育、细胞凋亡)、分子生物学(基因表达调控)领域炙手可热的模式生物“秀丽隐杆线虫”为培养和研究的对象,按照斯坦福大学的培养模式组织教学和学生的创新科研活动,联合探索培养中学阶段生物领域的创新人才模式与路径。
我校的斯坦福生物项目研究社团以课程和活动为主要内容,由实验教学经验丰富、具科研经历的教师组织承担,还不定期邀请中科院生物物理研究所专家教授对学生以及课程教师进行辅导、培训,师资力量雄厚。

北京新闻中对中共北京市委书记蔡奇
访潞河时观摩线虫实验课的报道


宽敞明亮的实验室和先进的实验设备
斯坦福生物项目研究社团为学生介绍线虫的相关背景知识,并对相关的实验技能进行培训,在此基础上以线虫为对象开展学生感兴趣的各种研究以体验完整的科学研究过程。按照课程的设置,学生在创新实验中要经历“选题”、“开题”、“推进”、“中期报告”、“结题”、“成果交流”等环节,在期间进行文献查阅、方法确立、实验设计、实验操作、结果观察、数据分析、交流汇报、论文撰写等训练,教师充分尊重学生的想法,并进行较为专业的指导。

中科院王香明教授
对学生进行开题指导
该社团活动除在校本课定期开设外,在社团活动时间或周六、日等也会根据学生实验进展的需求开放实验室。为了体现科研的一贯性、持续性,本学年线虫科研创新活动社团将学习小组调整为“老带新”模式,老社员带新社员熟悉实验操作,新社员延续老社员未完成课题,使科学问题的解决有始有终。

制作工具-铂金丝小铲

在超净工作台进行线虫传代培养

用显微镜观察、鉴别线虫
线虫——妥妥的“工具”
脑洞大开的实验设计
录制线虫学习行为的实验操作
受疫情影响,线虫实验一度中止。在线上教学期间,我们通过阅读线虫操作手册和线虫研究历史的文献,充分了解线虫培养必备的实验技能和实验方法,为下学期即将开展的课题研究打下坚实的基础,同时提升社员的文献阅读能力。通过专家讲座开拓视野,深入了解模式生物在遗传学研究中的重要作用。下学期社团的活动计划包括新课题的开题、老课题的结题以及论文的撰写,期待在2023年的金鹏科技论坛和青少年科技创新大赛中能看到我们社员的优秀成果。
![]() |
![]() |
| 研读英文文献 |
观看北京大学 钱伟强教授线上讲座 |
自从斯坦福生物项目研究社团开展以来,大多数学生在研究实践中得到了深入的体验,也有部分同学获得了较为深入的实验成果。以下是已有成果的展示,也是我们未来奋斗追逐以及超越的目标!

学生获奖
北京市青少年科技创新三等奖

学生获奖
各种科技类比赛区赛成绩
如果你热爱生物学科,请随我们一起体验这做科研的快乐吧,可能过程不会一帆风顺,但是你一定会收获满满。
校园欺凌举报电话:宋久峰老师 69557421
北京市通州区潞河中学版权所有 Copyright © 2026 https://www.luhe.cn All rights reserved.
京ICP备05037833号技术支持:新网

